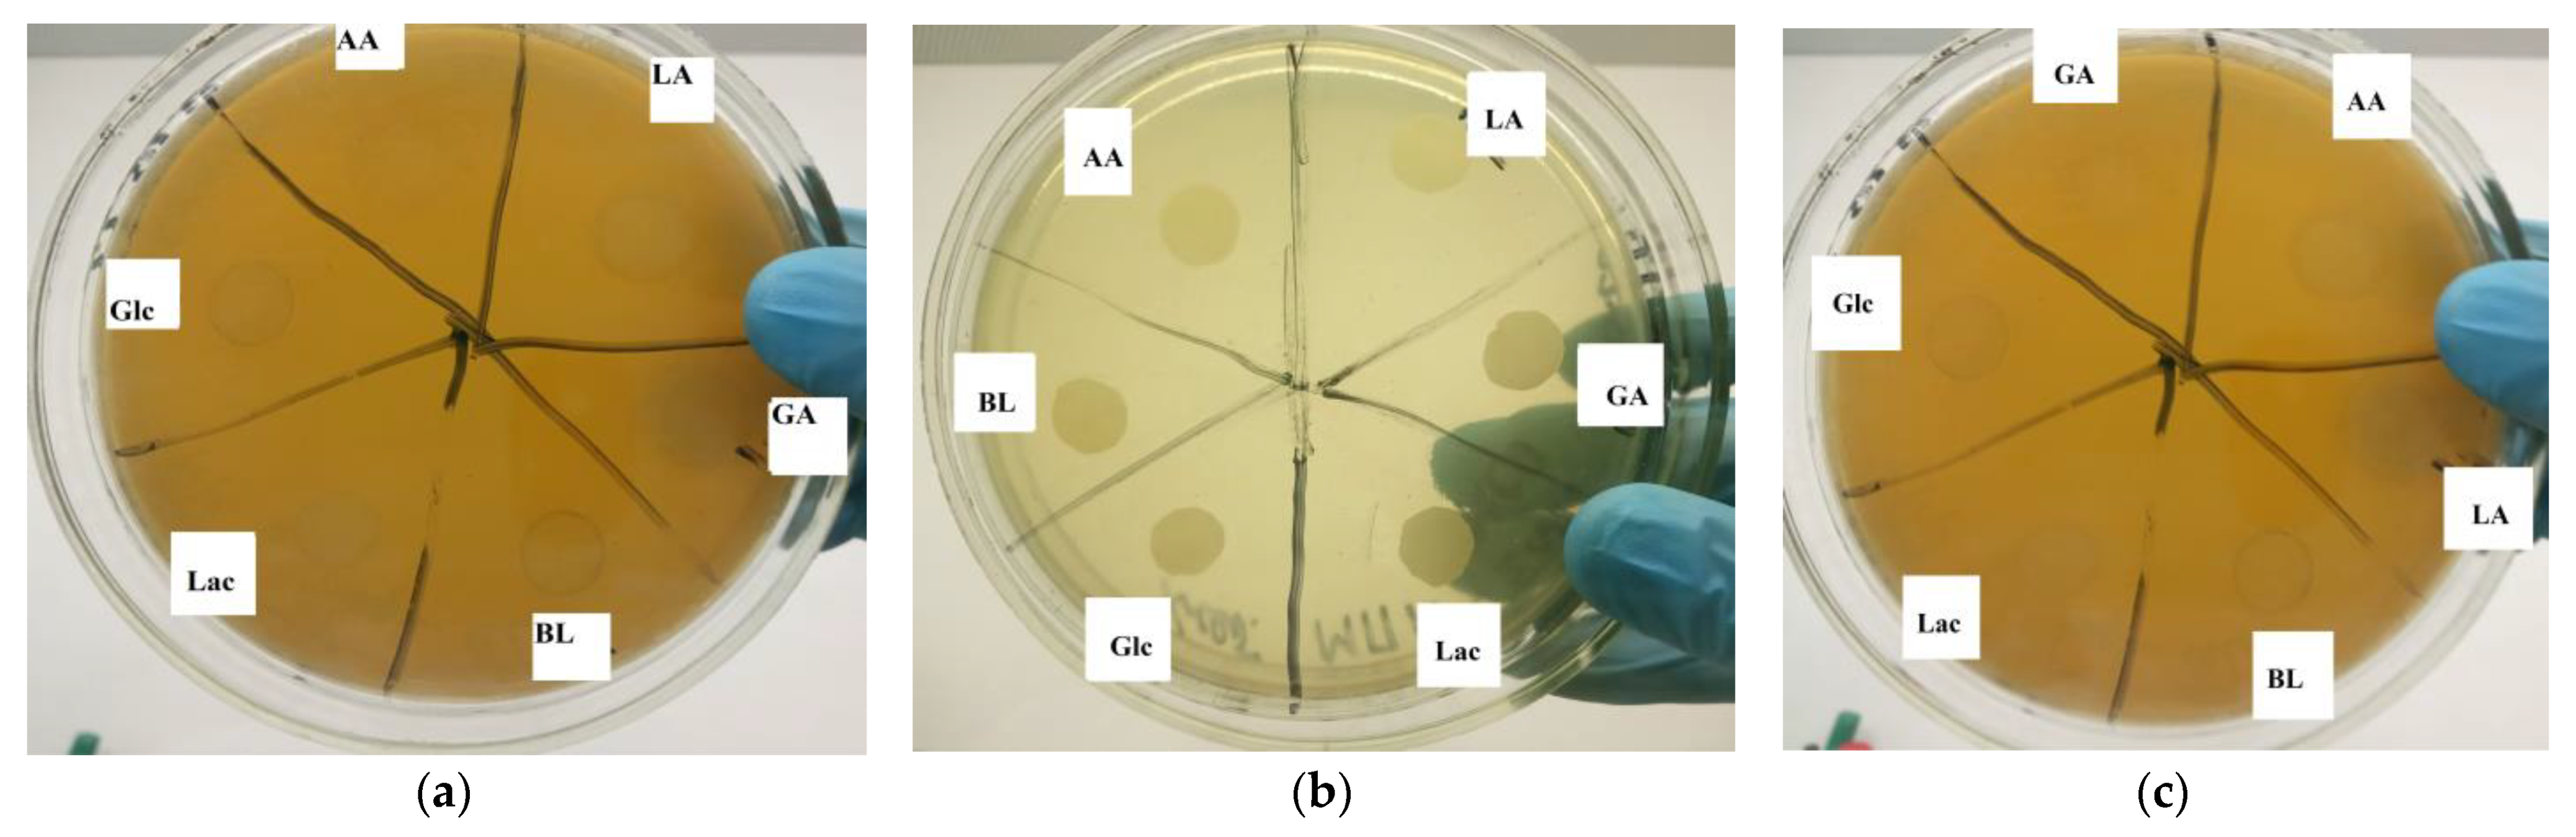
Materials 17 00981 g014

New Biodegradable Copolymers Based on Betulin and Hydroxycarboxylic Acid Derivatives
Abstract
1. Introduction
2. Experimental Section
2.1. Materials
2.2. Methods
3. Results and Discussion
4. Conclusions
5. Patents
Author Contributions
Funding
Institutional Review Board Statement
Informed Consent Statement
Data Availability Statement
Acknowledgments
Conflicts of Interest
References
- Tolstikov, G.A.; Flekhter, O.B.; Shultz, E.E.; Baltina, L.A.; Tolstikov, A.G. Betulin and Its Derivatives. Chemistry and Biological Activity. Chem. Sustain. Dev. 2005, 13, 1–29. [Google Scholar]
- Jonnalagadda, S.C.; Suman, P.; Morgan, D.C.; Seay, J.N. Recent Developments on the Synthesis and Applications of Betulin and Betulinic Acid Derivatives as Therapeutic Agents. In Studies in Natural Products Chemistry; Elsevier B.V.: Amsterdam, The Netherlands, 2017; Volume 53, pp. 45–84. ISBN 9780444639301. [Google Scholar]
- Kislitsyn, A.N. Birch Bark Extractives: Isolation, Composition, Properties, Application. Chem. Wood 1994, 3, 325–341. (In Russian) [Google Scholar]
- Niewolik, D.; Bednarczyk-Cwynar, B.; Ruszkowski, P.; Sosnowski, T.R.; Jaszcz, K. Bioactive Betulin and Peg Based Polyanhydrides for Use in Drug Delivery Systems. Int. J. Mol. Sci. 2021, 22, 1090. [Google Scholar] [CrossRef]
- Ma, Z.; Jia, Y.G.; Zhu, X.X. Glycopolymers Bearing Galactose and Betulin: Synthesis, Encapsulation, and Lectin Recognition. Biomacromolecules 2017, 18, 3812–3818. [Google Scholar] [CrossRef]
- Gorbunova, M.N.; Krainova, G.F. Triterpene-Containing Polymer Structures: Synthesis and Biological Activity. Bull. Perm Sci. Cent. 2014, 2, 44–52. (In Russian) [Google Scholar]
- Niewolik, D.; Krukiewicz, K.; Bednarczyk-Cwynar, B.; Ruszkowski, P.; Jaszcz, K. Novel Polymeric Derivatives of Betulin with Anticancer Activity. RSC Adv. 2019, 9, 20892–20900. [Google Scholar] [CrossRef] [PubMed]
- Chen, Y.; Song, Q.; Zhao, J.; Gong, X.; Schlaad, H.; Zhang, G. Betulin-Constituted Multiblock Amphiphiles for Broad-Spectrum Protein Resistance. ACS Appl. Mater. Interfaces 2018, 10, 6593–6600. [Google Scholar] [CrossRef] [PubMed]
- Jeromenok, J.; Bchlmann, W.; Jager, C.; Weber, J. Carbon Dioxide Adsorption in Betulin-Based Micro-and Macroporous Polyurethanes. ChemistryOpen 2013, 2, 17–20. [Google Scholar] [CrossRef] [PubMed]
- Huang, T.; Li, D.; Ek, M. Water Repellency Improvement of Cellulosic Textile Fibers by Betulin and a Betulin-Based Copolymer. Cellulose 2018, 25, 2115–2128. [Google Scholar] [CrossRef]
- Huang, T.; Chen, C.; Li, D.; Ek, M. Hydrophobic and Antibacterial Textile Fibres Prepared by Covalently Attaching Betulin to Cellulose. Cellulose 2019, 26, 665–677. [Google Scholar] [CrossRef]
- Auclair, N.; Kaboorani, A.; Riedl, B.; Landry, V. Acrylated Betulin as a Comonomer for Bio-Based Coatings. Part II: Mechanical and Optical Properties. Ind. Crops Prod. 2016, 82, 118–126. [Google Scholar] [CrossRef]
- Okada, M.; Suzuki, K.; Mawatari, Y.; Tabata, M. Biopolyester Prepared Using Unsaturated Betulin (Betulinol) Extracted from Outer Birch Bark and Dicarboxylic Acid Dichlorides and Its Thermal-Induced Crosslinking. Eur. Polym. J. 2019, 113, 12–17. [Google Scholar] [CrossRef]
- Curia, S.; Dautle, S.; Satterfield, B.; Yorke, K.; Cranley, C.E.; Dobson, B.E.; La Scala, J.J.; Soh, L.; Gordon, M.B.; Stanzione, J.F. Betulin-Based Thermoplastics and Thermosets through Sustainable and Industrially Viable Approaches: New Insights for the Valorization of an Underutilized Resource. ACS Sustain. Chem. Eng. 2019, 7, 16371–16381. [Google Scholar] [CrossRef]
- Erä, V.A.; Jääskeläinen, P.; Ukkonen, K. Polyurethanes from Betulinol. Angew. Makromol. Chem. 1980, 88, 79–88. [Google Scholar] [CrossRef]
- Vasnev, V.V.; Konkina, I.N.; Korshak, V.V.; Vinogradova, S.V.; Lindberg, J.J.; Jääskeläinen, P.; Piiroinen, K. Syntheses of Unsaturated Polyesters Containing Betulinol Moieties. Makromol. Chem. 1987, 188, 683–691. [Google Scholar] [CrossRef]
- Nemilova, V.E.; Nachinkin, O.N.; Tsarev, G.I. Polyesters Based on Betulin and Adipic Acid. Polym. Physicochem. 1996, 2, 124–127. (In Russian) [Google Scholar]
- Orlova, T.V.; Nemilov, V.E.; Tsarev, G.I.; Vojtova, N.V. Method of Preparing Betulin-Based Polyethers. RU Patent 2167892 C1, 27 May 2001. [Google Scholar]
- Xiaobo, X.; Xiaozhen, M.; Xiaolin, W.; Jin, Z.; Jinggang, W.; Ning, Y.; Jing, C. Catalyst-Free Synthesis of Betulin-Based Polyurethane Elastomers with Outstanding Mechanical Properties and Solvent Resistance. ACS Appl. Polym. Mater. 2023, 5, 8260–8269. [Google Scholar] [CrossRef]
- Lehman-Chong, A.M.; Cox, C.L.; Kinaci, E.; Burkert, S.E.; Dodge, M.L.; Rosmarin, D.M.; Newell, J.A.; Soh, L.; Gordon, M.B.; Stanzione, J.F. Itaconic Acid as a Comonomer in Betulin-Based Thermosets via Sequential and Bulk Preparation. ACS Sustain. Chem. Eng. 2023, 11, 14216–14225. [Google Scholar] [CrossRef]
- Grigoreva, A.; Kolobova, E.; Pakrieva, E.; Mäki-Arvela, P.; Carabineiro, S.A.C.; Gorbunova, A.; Bogdanchikova, N.; Murzin, D.Y.; Pestryakov, A. Supported Silver Nanoparticles as Catalysts for Liquid-Phase Betulin Oxidation. Nanomaterials 2021, 11, 469. [Google Scholar] [CrossRef]
- Takibayeva, A.T.; Zhumabayeva, G.K.; Bakibaev, A.A.; Demets, O.V.; Lyapunova, M.V.; Mamaeva, E.A.; Yerkassov, R.S.; Kassenov, R.Z.; Ibrayev, M.K. Methods of analysis and identification of betulin and its derivatives. Molecules 2023, 28, 5946. [Google Scholar] [CrossRef]
- Floor, M.; Kieboom, A.P.G.; van Bekkum, H. Alumina- and Y-zeolite-catalyzed Reaction of Cyclohexanol with Tert-butylhydroperoxide. Recl. Trav. Chim. Pays-Bas 1988, 107, 362–365. [Google Scholar] [CrossRef]

| № | Polymer Materials | Substrates, Conditions | Yield (%) | Ref. |
|---|---|---|---|---|
| 1 | Polyanhydrides | 1. Synthesis of disuccinate betulin (DBB): betulin, pyridine, succinic anhydride, heat, 8 h 2. Synthesis of copolymers DBB and PEG: DBB, derivatives of PEG, acetic anhydride, 150 °C, ~ 3 h, N2 → vacuum | 90 | [4] |
| 2 | Glycopolymers | 1. Synthesis of betulin-based methacrylate monomer (MBet): betulin, 4-(dimethylamino)pyridine, CH2Cl2, methacrylic anhydride, room temperature, 24 h 2. Synthesis of random and block copolymers: MBet, 6-O-Methacryloyl-1,2:3,4-di-O-isopropylidene-D-galactopyranose (MIpGa), 4-Cyano-4- [(propylsulfanylthiocarbonyl)sulfanyl]pentanoic acid (CTA), 2,2′-azoisobutyronitrile (AIBN), 75 °C, overnight/10 h | n.d. | [5] |
| 3 | Triterpene-containing polymer constructions | 1. Synthesis of 28-O-maleate of betulin (MB): betulin, maleic acid, dicyclohexylcarbodiimide 2. Radical polymerization: MB and N-vinylpyrrolidone (VP) or acrylonitrile (AN) or vinyl acetate (VA) in the presence of dinitrile azobisisobasic acid (DAA), 70 °C | n.d. | [6] |
| 4 | Betulin-constituted multiblock amphiphiles | 1. Synthesis of betulin-doped poly(ethylene oxide) (BEO): betulin, tetrahydrofuran, t-BuP4, ethylene oxide, phosphazenium salt, 45 °C 2. Synthesis of betulin-doped poly(ethylene oxide)-polyurethane (BEO-PU): BEO, toluene, isophorone diisocyanate (IPDI), diphenyl phosphate (DPP), triethylamine, 60 °C, 3 days | n.d. | [8] |
| 5 | Micro- and macroporous polyurethanes | Triphenylmethane triisocyanate in ethyl acetate, betulin in toluene, 110 °C, reflux, 1.5 h | 92 | [9] |
| 6 | Betulin-terephthaloyl chloride | Betulin, terephthaloyl chloride toluene, pyridine, 105 °C, 24 h | n.d. | [10] |
| 7 | Bio-based coatings | 1. Synthesis of acrylated betulin (AB): betulin, THF, pyridine, acryloyl chloride, ~2 h 2. AB, acrylated epoxidized soybean oil (AESO), Darocur 1173 (2-hydroxy-2-methyl-phenyl-propanone) | n.d. | [12] |
| 8 | Aliphatic biopolyester | Betulin, aliphatic acid dichlorides (succinyl chloride, adipoyl chloride, pimeloyl chloride, azelaoyl chloride, sebacoyl chloride, dodecanedioyl chloride), pyridine, THF, N2, 25 °C, 15 h | 85–91 | [13] |
| 9 | Thermoplastic polyesters | Betulin, diacid comonomer (succinic acid (SAc), adipic acid (AAc), 1,12- dodecanedioic acid (DDDAc), 1,18-octadecanedioic acid (ODDAc)), dibutyltin oxide (DBTO), 180 °C, Ar → vacuum, 24–72 h | 70–92 | [14] |
| 10 | Thermosetting polyesters | Betulin, SAc, AAc or DDDAc, glycerol, dibutyltin dilaurate, vacuum at 190 °C → atmospheric pressure at 150 °C | 70–92 | [14] |
| 11 | Polyurethanes | Betulin, Desmodur E 22 (aromatic polyisocyanate prepolymer based on diphenylmethane diisocyanate), dibutyltin dilaurate, toluene, N2, 110 °C, 10–60 h | n.d. | [15] |
| 12 | Unsaturated polyesters | 1. Synthesis of unsaturated oligomers: betulin, diethylene glycol, maleic anhydride, Ar, 200 °C, 1 h 2. Copolymerization: oligomer, styrene, ethyl methyl ketone peroxide, cobalt naphthenate, room temperature, atmospheric pressure | n.d. | [16] |
| 13 | Polyesters | Betulin, pimelic, azelaic or sebacic acids, N2 or vacuum, 256–260 °C, 22–24 h | 86–97 | [18] |
| 14 | Polyurethane elastomers | Betulin, castor oil, N2, 60-120 °C, 10h | n.d. | [19] |
| 15 | Thermosets | 1. Synthesis of thermoplastic polyester: betulin, diacid, itaconic acid, dibutyltin oxide, 180 °C, Ar → vacuum, 48 h 2. Synthesis of polyester-methacrylate thermoset: thermoplastic polyester, mono-methacrylate, diphenyl(2,4,6- trimethylbenzoyl)phosphine oxide, UV | n.d. | [20] |
| Sample | Observed Phase (Framework) | Specific Surface Area (SBET), m2/g | Pore Size, nm | Pore Volume, cm3/g |
|---|---|---|---|---|
| γ-Al2O3 | gamma-alumina (cubic) | 274 | 11.7 | 1.14 |
| Comonomer | MnGPC, g·mol−1 | MwGPC, g·mol−1 | Yield, % |
|---|---|---|---|
| AA | 1600 | 1900 | 75 |
| LA | 500 | 500 | - |
| GA | - | - | - |
| Comonomer | MnGPC, g·mol−1 | MwGPC, g·mol−1 | Yield, % |
|---|---|---|---|
| Lac | 800 | 900 | 73 |
| Glc | 750 | 900 | 71 |
| BL | 500 | 750 | 96 |
| Comonomer | Time, h | γ-Al2O3 | γ-Al2O3/TBHP | ||||
|---|---|---|---|---|---|---|---|
| MnGPC, g·mol−1 | MwGPC, g·mol−1 | Yield, % | MnGPC, g·mol−1 | MwGPC, g·mol−1 | Yield, % | ||
| Lac | 3 | 800 | 900 | 73 | 1000 | 1300 | 76 |
| Lac | 15 | 1200 | 2200 | 75 | 1300 | 2300 | 78 |
| Lac | 24 | 1600 | 3100 | 75 | 1600 | 3100 | 78 |
| Glc | 3 | 750 | 900 | 71 | 1200 | 2300 | 72 |
| Glc | 15 | 1000 | 1400 | 72 | 1100 | 1600 | 73 |
| Glc | 24 | 1600 | 1600 | 71 | 1300 | 2900 | 75 |
| BL | 3 | 500 | 700 | 96 | 1500 | 1900 | 92 |
| BL | 15 | 3000 | 4100 | 95 | 5300 | 11800 | 98 |
| BL | 24 | 5600 | 6000 | 95 | 6900 | 7200 | 91 |
| Catalyst | MnGPC, g·mol−1 | MwGPC, g·mol−1 | Yield, % |
|---|---|---|---|
| without catalyst | 500 | 500 | 75 |
| γ-Al2O3 | 5600 | 6000 | 93 |
| γ-Al2O3/TBHP | 6900 | 9500 | 91 |
| Sn(Oct)2 | 5500 | 4400 | 25 |
| Zn(OAc)2 | 4300 | 4100 | 47 |
Disclaimer/Publisher’s Note: The statements, opinions and data contained in all publications are solely those of the individual author(s) and contributor(s) and not of MDPI and/or the editor(s). MDPI and/or the editor(s) disclaim responsibility for any injury to people or property resulting from any ideas, methods, instructions or products referred to in the content. |
© 2024 by the authors. Licensee MDPI, Basel, Switzerland. This article is an open access article distributed under the terms and conditions of the Creative Commons Attribution (CC BY) license (https://creativecommons.org/licenses/by/4.0/).
Share and Cite
Zinovyev, A.; Gorbunova, A.; Chernova, A.; Carabineiro, S.A.C.; Poletykina, E.; Bugaeva, A.; Novikov, V.; Kolobova, E.; Pestryakov, A. New Biodegradable Copolymers Based on Betulin and Hydroxycarboxylic Acid Derivatives. Materials 2024, 17, 981. https://doi.org/10.3390/ma17050981
Zinovyev A, Gorbunova A, Chernova A, Carabineiro SAC, Poletykina E, Bugaeva A, Novikov V, Kolobova E, Pestryakov A. New Biodegradable Copolymers Based on Betulin and Hydroxycarboxylic Acid Derivatives. Materials. 2024; 17(5):981. https://doi.org/10.3390/ma17050981
Chicago/Turabian StyleZinovyev, Alexey, Alina Gorbunova, Anna Chernova, Sónia A. C. Carabineiro, Ekaterina Poletykina, Anastasia Bugaeva, Viktor Novikov, Ekaterina Kolobova, and Alexey Pestryakov. 2024. "New Biodegradable Copolymers Based on Betulin and Hydroxycarboxylic Acid Derivatives" Materials 17, no. 5: 981. https://doi.org/10.3390/ma17050981
APA StyleZinovyev, A., Gorbunova, A., Chernova, A., Carabineiro, S. A. C., Poletykina, E., Bugaeva, A., Novikov, V., Kolobova, E., & Pestryakov, A. (2024). New Biodegradable Copolymers Based on Betulin and Hydroxycarboxylic Acid Derivatives. Materials, 17(5), 981. https://doi.org/10.3390/ma17050981

